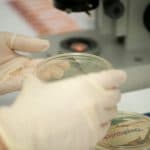
Kultur

Dermatolog in Lippstadt (Kernstadt), Germany
Marktstr. 13
59555 Lippstadt (Kernstadt)
Montag: 08:00-13:00 Dienstag: 08:00-16:00 Mittwoch: 08:00-13:00 Donnerstag: 08:00-16:00 Freitag: 08:00-10:00 Samstag: auf Anfrage
Dr. med. Funda Schürmeyer-Horst ist Ihre erfahrene Fachärztin für Dermatologie in Lippstadt (Kernstadt). In unserer Praxis in der Marktstr. 13 bieten wir Ihnen ein umfassendes Leistungsspektrum der modernen Dermatologie und Venerologie. Schwerpunkte bilden die Hautkrebsvorsorge mit modernster Technik (Fotofinder), die Allergologie sowie operative Eingriffe im Bereich der operativen Dermatologie. Darüber hinaus sind wir Ihr kompetenter Ansprechpartner für Berufsdermatologie und bieten Ihnen individuelle Gesundheitsleistungen. Im Bereich der medizinischen und ästhetischen Kosmetik offerieren wir Ihnen Microneedling und weitere Behandlungen für ein gesundes und schönes Hautbild. Vereinbaren Sie Ihren Termin bei Ihrem Hautarzt in Lippstadt – für eine umfassende und individuelle Betreuung Ihrer Hautgesundheit. Wir freuen uns auf Ihren Besuch!

Exzellente Betreuung
Meine gesamte Familie geht hierher. Zuverlässige Diagnosen und immer freundliche Atmosphäre in der Praxis.
Gründliche Untersuchung
Sehr kompetenter Dermatologe. Die Untersuchung war gründlich und der Arzt hat sich viel Zeit genommen, alles zu erklären.
Moderne Ausstattung
Toller Arzt, der einem die Angst nimmt. Alles wurde verständlich erklärt und die Behandlung war schmerzfrei.
Exzellente Betreuung
Nach langer Suche endlich einen Hautarzt gefunden, dem ich vertraue. Gründlich, kompetent und menschlich.